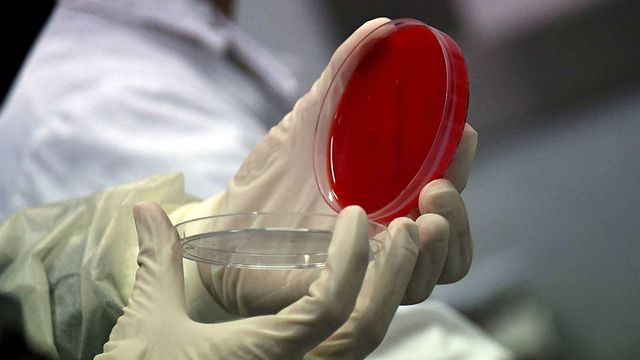

Una bambina di due anni è stata ricoverata in gravi condizioni all’Ospedale Sant’Orsola di Bologna per le complicazioni di una meningite tubercolare, una forma rara e severa di infezione provocata dal Mycobacterium tuberculosis. Di concerto con l'Ausl, il comune di Santa Sofia (Forlì-Cesena, dove la piccola vive assieme alla madre) ha attivato un protocollo di sicurezza per scongiurare la presenza di altri casi e la diffusione dell’infezione.
Cos'è la meningite tubercolare?
La meningite tubercolare è una forma rara e aggressiva di infezione dovuta al Mycobacterium tuberculosis, un batterio che colpisce le membrane (meningi) attorno al cervello e al midollo spinale.
Come si trasmette?
Si trasmette per via aerea, tramite le secrezioni respiratorie emesse da un individuo contagioso, come saliva, starnuto o colpo di tosse. Il contagio, però, non è semplice, perché si devono verificare una serie di condizioni contemporanee: una carica batterica molto alta, una tubercolosi polmonare attiva e contatti stretti e prolungati.
Quali sono i sintomi?
I primi sintomi della meningite tubercolare possono essere vaghi e vengono spesso confusi con altre malattie. Quelli comuni includono forte mal di testa, febbre, nausea, vomito e torcicollo. Man mano che la malattia progredisce, possono comparire sintomi più gravi come confusione o stato mentale alterato, sensibilità alla luce, convulsioni e perdita di conoscenza. Riconoscere precocemente questi sintomi è fondamentale per una diagnosi e un trattamento tempestivi, riducendo potenzialmente il rischio di complicanze a lungo termine. Chi risulta positivo al primo test, non è necessariamente ammalato. La positività al test indica soltanto che la persona è entrata in contatto con il bacillo responsabile della malattia in un periodo della vita e che ciò ha determinato una reazione di difesa immunitaria. In caso di positività al test vengono eseguiti ulteriori accertamenti diagnostici.
Come si fa la diagnosi?
La diagnosi di meningite tubercolare prevede diversi passaggi. I metodi diagnostici essenziali includono: analisi del liquido cerebrospinale, l'imaging (risonanza magnetica o scansioni CT), test microbiologici (come il PCR).
Come si cura?
Se colpiti da meningite tubercolare, bisogna innanzitutto rivolgersi a un medico che prescriverà una combinazione di antibiotici e terapia di supporto (somministrazione di corticosteroidi, trattamento sintomatico e supporto nutrizionale) per eliminare l’infezione e ridurre l’infiammazione.